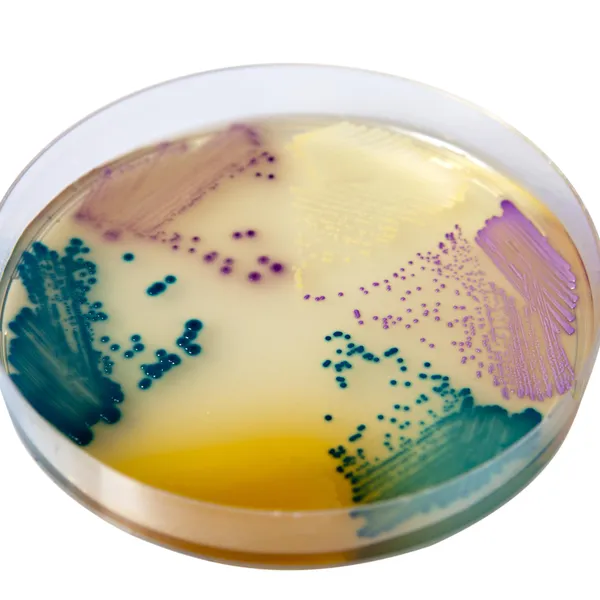
CHROMagar™ Orientation

Hình thái khuẩn lạc

E. coli
Hồng đậm đến đỏ

Enterococcus
Xanh ngọc lam

Proteus
Quầng nâu

Klebsiella, Enterobacter, Serratia
Xanh kim loại

S. aureus
Vàng, đục, nhỏ

Citrobacter
Xanh kim loại với quầng đỏ

S. saprophyticus
Hồng, đục, nhỏ

Candida albicans
Không màu

Streptococcus agalactiae
Xanh nhạt

Pseudomonas aeruginosa
Trong suốt, kem đến xanh
Hiệu năng
Hiệu năng
Nhiễm trùng đường tiết niệu (UITs) là một vấn đề sức khỏe cộng đồng nghiêm trọng. Tới 40% phụ nữ sẽ phát triển UTIs ít nhất một lần trong đời, và một số đáng kể trong số này sẽ có nhiễm trùng tiết niệu tái phát. Do đó, bất kỳ sự giảm tải công việc nào liên quan đến phân tích này sẽ cải thiện đáng kể hiệu suất của phòng lab.
Mục đích sử dụng :
CHROMagar™ Orientation là môi trường nuôi cấy chromogen không chọn lọc dùng để phát hiện định tính trực tiếp, phân biệt và nhận dạng sơ bộ các tác nhân gây bệnh đường tiết niệu nhằm hỗ trợ chẩn đoán nhiễm trùng đường tiết niệu. Xét nghiệm được thực hiện với mẫu nước tiểu. Kết quả có thể được diễn giải sau 18-24 giờ ủ hiếu khí ở 35-37 °C.
Việc nuôi cấy đồng thời là cần thiết để thu hồi các vi sinh vật cho các thử nghiệm vi sinh học hoặc phân loại dịch tễ học thêm. Sự thiếu tăng trưởng hay sự vắng mặt của khuẩn lạc trên CHROMagar™ Orientation không loại trừ sự hiện diện của vi khuẩn. CHROMagar™ Orientation không nhằm chẩn đoán nhiễm trùng hoặc hướng dẫn hay theo dõi điều trị nhiễm trùng.
CHROMagar™ Orientation cũng có thể được sử dụng với các mẫu vật y tế thú y.
1. Bảng màu ngay lập tức để đạt được phân biệt lớn về loài:
CHROMagar™ Orientation có một số lợi thế so với các môi trường truyền thống :
- cho phép trong hầu hết các trường hợp phân biệt hoàn toàn các tác nhân gây bệnh,
- cho phép đánh giá bán định lượng và nhận dạng sơ bộ các tác nhân gây bệnh đường tiết niệu,
- cho phép dễ dàng nhận biết sự phát triển hỗn hợp,
- cung cấp tỷ lệ phát hiện cao hơn.
2. Phát hiện cao các quần thể nhỏ: Việc sử dụng đúng cách CHROMagar™ Orientation sẽ xác định chính xác sự hiện diện của quần thể nhỏ và sẽ giúp thiết lập chẩn đoán và liệu pháp điều trị đúng đắn.
3. Tiết kiệm thời gian và giảm tải công việc:
Tác nhân gây bệnh UTI thông thường nhất là E. coli, được tìm thấy trong 40-70% các trường hợp nhiễm trùng. CHROMagar™ Orientation có độ đặc hiệu 99,3%* cho E. coli.
Một đĩa CHROMagar™ Orientation sẽ cho cùng thông tin như sự kết hợp của 3 đĩa truyền thống dùng cho phân tích UTI (thạch máu, CLED và thạch MacConkey). Hơn nữa, vì dễ dàng phân biệt vi hệ hỗn hợp trên CHROMagar™ Orientation, các thử nghiệm nhạy cảm kháng khuẩn có thể được thực hiện trực tiếp từ các mẫu phân lập chính mà không cần nuôi cấy thêm.**

Thành phần

Tài liệu kỹ thuật
Công bố khoa học
2023
Zoonotic Staphylococcus spp. among domestic animals in Ukraine: antibiotic resistance and diagnostic approaches
📄 Publication2023
Identificación presuntiva simplificada de Enterobacterales mediante CHROMagar™ Orientation y pruebas bioquímicas mínimas
📄 Publication2022
Bacterial Content in Gut For Different Species of Fish Collecting From Tigris River in Baghdad City, Iraq
📄 Publication2022
Bloodstream Infections caused by Magnusiomyces capitatus and Magnusiomyces clavatus: Epidemiological, Clinical, and Microbiological Features of Two Emerging yeast species
📄 Publication2021
Comparison of CHROMagar Orientation versus CLED (cystine-lactose-electrolyte-deficient) Agar, VITEK-XL and MALDI-TOF in a tertiary laboratory setting processing Urine culture samples at Dr. Lal Path Labs, Delhi
📄 Publication2021
A prospective multicentre surveillance study to investigate the risk associated with contaminated sinks in the intensive care unit
📄 Publication2017
Impact of selective media for detecting fluoroquinolone-insusceptible/ extended-spectrum beta-lactamase-producing Escherichia coli before transrectal prostate biopsy
📄 Publication2016
Rapid and efficient approach to urine culture screening using CHROMagar Orientation/ESBL medium
📄 Publication2016
Accuracy and Cost-Effectiveness of the CHROMagar Orientation/ ESBL medium for Identification and Detection of Extended-Spectrum B-Lactamase (ESBL)-Producing Gram-Negative Bacilli in comparison to conventional methodology and Mass Spectrometry
📄 Publication2016
Isolation and Identification of some Bacterias Causing Lung Abscesses in Sheep With Chromogenic Media
📄 Publication2016
Comparison of three diagnostic methods for Acinetobacter baumannii isolated from Baghdad Hospitals
📄 Publication2014
Validation of Susceptibility Testing Results from Organisms Isolated Directly from Colorex Orientation Agar ECCMID 2014
📄 Publication2013
Validation of Direct Inoculation of Urinary pathogens from Alere Orientation Agar to Vitek 2 and Phoenix Identification panels and to Vitek MS (MALDITOF) (with Susceptibility Testing)
📄 Publication2013
Comparison of CPS ID 3 and CHROMagar Orientation chromogenic agars with standard biplate technique for culture of clinical urine samples. ABSTRACT
📄 Publication2013
Evaluation of Chromogenic Media for the Work-up of Urine Specimens: Comparison of chromIDTM CPS®, BBL™ CHROMagarTM and Colorex Orientation™ to Conventional Urine Culture Method
📄 Publication2012
Reduction in workload by use of CHROMagar Orientation™ for urine cultures compared to the use of Blood Agar/MacConkey agar split plate
📄 Publication2009
Use of chromogenic agar in detection of urinary tract pathogens and antimicrobial susceptibility
📄 Publication2004
Urocultivos: Optimizacion de recursos en el diagnostico de infecciones urinarias en pediatra (poster in spanish)
📄 Publication2002
Comparative evaluation of two commercial chromogenic media for detection and presumptive identification of urinary tract pathogens
📄 Publication2002
Performance of four chromogenic urine culture media after one or two days of incubation compared with reference media. Olle Aspevall, Bjorn Osterman et al.
📄 Publication2000
Cost-effective and rapid presumptive identification of Gram negative bacilli in routine urine, pus and stool cultures: Evaluation of the use of CHROMagar Orientation medium in conjunction with simple biochemical tests
📄 Publication1999
The use of CHROMagar Orientation as a primary isolation medium with presumptive identification for the routine screening of urine specimens
📄 Publication1998
Evaluation of use of a new chromogenic agar in detection of urinary tract pathogens
📄 Publication1998
Evaluation of CHROMagar Orientation medium for the identification of surveillance cultures: a novel method
📄 Publication1997
Application of CHROMagar Orientation in the identification and differentiation of Proteae from other Enterobacteriaceae
📄 Publication1997
Evaluation of a new medium for isolation, differentiation and presumptive identification of microorganisms in urinary tract infections
📄 Publication1996
Evaluation of CHROMagar Orientation for differentiation and presumptive identification of Gram negative bacilli and Enterococcus species
📄 Publication

Xem thêm